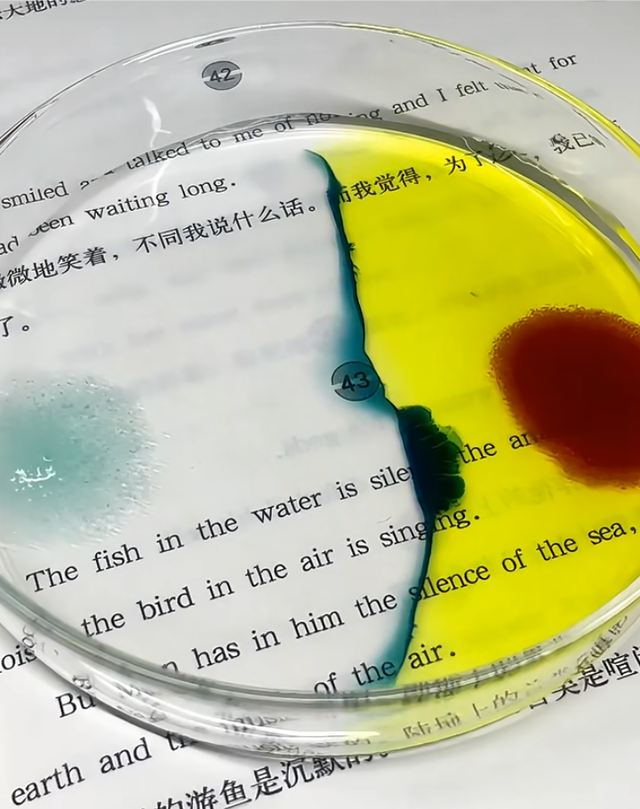

①
“头,这几天看了个化学博主,对你考试好,给你念…”,冷勾云翻了一下收藏夹,话没说完被大头打断
“远哥,我学文,合格考也考了,用不上”,王楚钦揉揉肩膀,这次胳膊拉伤,球也输了,有些闷
“还有水么你那”,王楚钦嗓子好像要冒火,早知道把那半瓶水拿上了
“没了”
“我这有”,莎莎在后排冒头,,从夹缝中送进瓶水,“头哥,没拆过”
“嗯,谢谢”,王楚钦犹豫两秒,还是接了过来
“没事没事”,莎莎声音脆脆的
“?,那是孙颖莎 ,你认识认识”,冷勾云抢过矿泉水,拧开瓶盖递给他
“我认识,说过几句话,教练说以后可能要配混双”,王楚钦接了矿泉水,“ 瓶盖我还是能拧得开的,你怎么认识的?”
“她经常跟着鳗鱼,鳗鱼不还是她监护人来着嘛”,林高远笑笑,又翻开收藏夹,“不考试也听听,吸收吸收知识”
铁氰化钾和硫酸亚铁反应生成蓝色沉淀,即腾士蓝
-看似停留在原地,实际爱早已蔓延-
-你本以为你们只是平平谈谈,可她却无声无息闯进了你的心-
“远哥,让我睡会儿呗”,王大头捂了他手机,皱着眉,看着很难受
“行,你休息,我发给鳗鱼”
后排的鳗鱼莎莎听到鳗鱼的名字,“咋了咋了”
“嘘”,冷勾云让她俩安静下来,然后让鳗鱼看手机
“好,抱歉,头哥,远哥”,莎莎也发现某头难受
②
混双课,大头练了几个发球,一旁的教练还在嘱咐莎莎“磨合磨合,实在不行配其他人”之类的话
给大头听的无语,我不就脾气差点嘛,还能把她吃了不成
“嘿,头哥”
“嗯,叫你莎莎,可以么,我听他们都这么叫”,王楚钦擦擦球拍,发现也不能像之前偶尔说话那样喊她孙颖莎,况且莎莎一直叫他头哥
“哈哈,随便叫”
“啧”
莎莎丢了一个球,被大头迷瞪了一眼
“啊,头哥,赖我赖我”
混双课结束,下面是午饭时间!,莎莎收完球拍,去邀请大头
“哥哥,一块吃饭啊”
“不用 ,我习惯一个人吃”
呦,高冷头
莎莎放好拍,也没放心上,蹦蹦跳跳去找鳗鱼了
③
莎莎嘛,像是明媚的小太阳,能把大家的情绪带起来;,又像是鲨鱼,打起球来有种韧劲;也像是豆沙包,外表看起来‘人畜无公害’,但实际上心眼子多着呢(褒义)
和莎莎配了月小一个月后,王楚钦觉得这个小女孩还挺可爱的
…
那次队内比赛 王楚钦输了球,简单把东西收拾好,就钻进了黑暗中,在一个角落静静地坐着
“嘿,哥哥”
莎莎走到他面前,手里拎着一排旺仔牛奶,然后掰了俩塞进王楚钦手里
“多大了还喝旺仔”
“还没成年都是小宝宝,成年了也是”
“谢了啊”,王楚钦拆了吸管,小喝了一口,“让我一个人待会儿呗”
“就当是,我想和你待会儿 ”,小莎挠挠头,“多喝点”
“嗯”
“头哥这次打不错啊,特别是那个摆短,还有你那个发球,哪天教教我呗”
少有灯光洒进来,王楚钦看到了莎莎的星星眼,对视两秒便慌忙移开
“头哥,你不会想哭吧”莎莎沉默两秒,“没事,你哭吧,我不会说出去的,男孩哭吧哭吧不是罪”
“还会唱歌呢,…,我这次打那么烂你还夸我,讽刺我呢”,王楚钦把牛奶放到一边,“我感觉打的还行,但还是差点”
“那咱就补回来,咱还年轻 ,不急”
“可我有点急 ,我想,再快点打出来”王楚钦染了哭腔
“你每次加练,每件湿透的训练服,磨平的鞋底,都是你努力的见证”莎莎说的认真,“按照你的步伐走下去,也许,你就是下一个世界冠军”
“所以别急,时机未到 等你全力以赴走完你该走的路,你一定会得到你最想要的 ”,莎莎拿着牛奶和王楚钦干杯
“现在呢,心情好点了嘛”
“好多了”,王楚钦站起来拍拍身上的土,伸出手想拉莎莎起来,“一块吃饭吗”
“不用,你习惯一个人吃”,莎莎拽着大头的手站起来,“你都拒绝我一次了,我也拒绝你一次”
“ 那,我再邀请你一次,莎莎同学,一块吃饭嘛”
“好,今天食堂有糖醋排骨”
那天,
莎莎是王楚钦心中最闪耀的月亮
未完